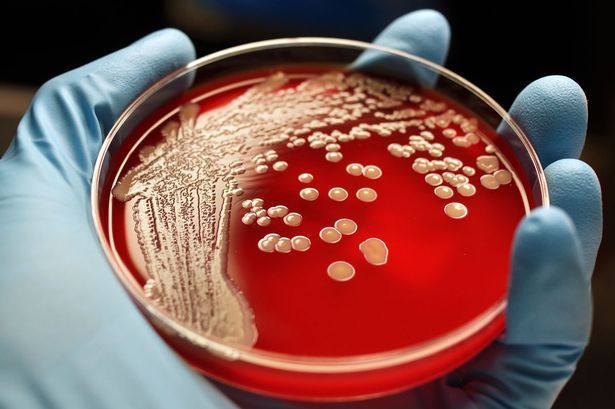
Siêu vi khuẩn đang là nỗi lo của rất nhiều người trên thế giới

Những căn bệnh lây nhiễm thông thường có thể trở thành kẻ giết người thầm lặng nếu không có những biện pháp kịp thời trong trận chiến chống lại các vi khuẩn kháng thuốc.
Đó là nhận định gần đây của các chuyên gia y tế.
Vi khuẩn có thể gây tử vong nhiều hơn số người chết vì ung thư nếu các chất kháng sinh không có khả năng vô hiệu chúng.
Nhiều chuyên gia y tế lo rằng cho tới năm 2050, mỗi năm sẽ có khoảng 10 triệu người chết vì siêu vi khuẩn.
Siêu vi khuẩn đang là nỗi lo của rất nhiều người trên thế giới
Lời cảnh báo nghiêm trọng này được đưa ra bởi George Osborne. Ông cho rằng, cuộc khủng hoảng kháng sinh này cũng sẽ tiêu tốn hơn 70,000 tỉ USD cho nền kinh tế thế giới trong vòng ba thế kỉ tới.
Về cơ bản, khi một loại kháng sinh được sử dụng nhiều lần, vi khuẩn sẽ trở nên “nhờn” với kháng sinh sau một thời gian dài.
Do đó, việc sử dụng kháng sinh sẽ không có tác dụng. Các nhà khoa học sẽ phải tìm ra một loại kháng sinh mới để phù hợp với loại siêu vi khuẩn mới ra đời.
Có khoảng 7,6 triệu người trên toàn thế giới qua đời mỗi năm vì căn bệnh ung thư. Chỉ tính riêng tại Anh, con số đó vào khoảng 160,000 người.
Tuy nhiên, các chuyên gia cho rằng, số lượng người chết có thể tăng lên 390,000 người mỗi năm do các loại thuốc không hiệu quả, cùng với 317,000 người tại Mỹ, 4 triệu người tại châu Phi và 4,7 triệu người khu vực châu Á.

Các loại vi khuẩn sau một thời gian sẽ trở nên “nhờn” thuốc kháng sinh
Chancellor trao đổi với quỹ tiền tệ thế giới tại Washington: “Nếu chúng ta không có những hành động mang tính toàn cầu, việc vi khuẩn trở nên “nhờn” với các loại thuốc kháng vi sinh vật (kháng kháng sinh) sẽ trở thành một mối đe dọa lớn hơn cả căn bệnh ung thư”.
Tổ chức y tế thế giới phát biểu rằng kháng kháng sinh “là một mối nguy lớn đối với y tế công cộng trên toàn cầu mà chúng ta cần hành động ngay để giải quyết chúng”.
“Nó đe dọa tới việc ngăn ngừa hiệu quả và điều trị nhiều loại dịch bệnh bởi vi khuẩn, nấm mốc, virus và các loại kí sinh trùng”.
Cảnh báo được đưa ra 2 năm về trước khi WHO dự đoán việc lạm dụng thuốc kháng sinh sẽ dẫn tới sự xuất hiện của vi khuẩn MRSA, một loại siêu vi khuẩn mà gần như không loại thuốc kháng sinh nào có thể điều trị được.

Nếu không có thuốc kháng sinh, khoảng 10 triệu người sẽ chết mỗi năm vì vi khuẩn
Trợ lý giám đốc an ninh sức khỏe Keiji Fukuda nói “Nếu không hành động kịp thời, thế giới đang dịch bước tới kỉ nguyên hậu kháng sinh, khi mà những căn bệnh tưởng chừng như đơn giản có thể gây tử vong”.
Nước Anh đã gây quỹ cho công tác nghiên cứu về việc bùng phát các vi khuẩn kháng kháng sinh. Năm ngoái, tổng thống Mỹ Barack Obama đã tiết lộ kế hoạch hành động trị giá 85 triệu USD để giải quyết vấn đề này.
Tuy nhiên, nhà vi sinh học nổi tiếng Hugh Pennington đã cảnh bảo: “Đây là trận chiến không có hồi kết. Chúng ta sẽ phát triển những loại thuốc kháng sinh mới.
Nhưng đó không phải là cách lâu dài khi mà với mỗi loại thuốc kháng sinh mới, các loại vi khuẩn lại phát triển để có thể kháng lại chất kháng sinh”.
Ông Osborne chia sẻ thêm: “Đây không phải chỉ là vấn đề sức khỏe mà còn liên quan tới vấn đề kinh tế. Chi phí liên quan tới việc nghiên cứu và phòng chống rất lớn.
Chúng ta cần tìm ra những phương pháp mới để điều trị, dưới sự hợp tác của chính phủ các nước và các công ty hàng đầu về dược phẩm”.

Các nhà nghiên cứu luôn nỗ lực để tìm ra các chất kháng sinh mới
“Chúng ta cần chuyển sự ưu tiên sang những giải pháp dài hạn hơn, đối với các công ty dược phẩm và nhiều tổ chức liên quan.
Những khoản đầu tư nên tập trung vào việc phát triển kháng sinh mới và đảm bảo khả năng tiếp cận các loại kháng sinh của người dân trên toàn thế giới”.
“Chúng ta cũng cần có những chẩn đoán chính xác hơn để hạn chế việc sử dụng chất kháng sinh”.
Kháng kháng sinh đang trở thành mối nguy toàn cầu và có thể dẫn tới ngày tàn đối với nền y học hiện đại khi mà sự phụ thuộc vào các loại thuốc kháng sinh hiệu quả cho nhiều loại bệnh là vô cùng lớn.
Sẽ cần có một kế hoạch hành động hợp lý và đồng bộ, từ việc tiêm chủng và kiểm soát lây nhiễm, nhằm giảm bớt sự lệ thuộc vào chất kháng sinh.
Chúng ta đang phải đối mặt với nguy cơ quay lại thời kì “tiền kháng sinh” nếu không có những loại thuốc mới phù hợp với các loại vi khuẩn hiện đại.